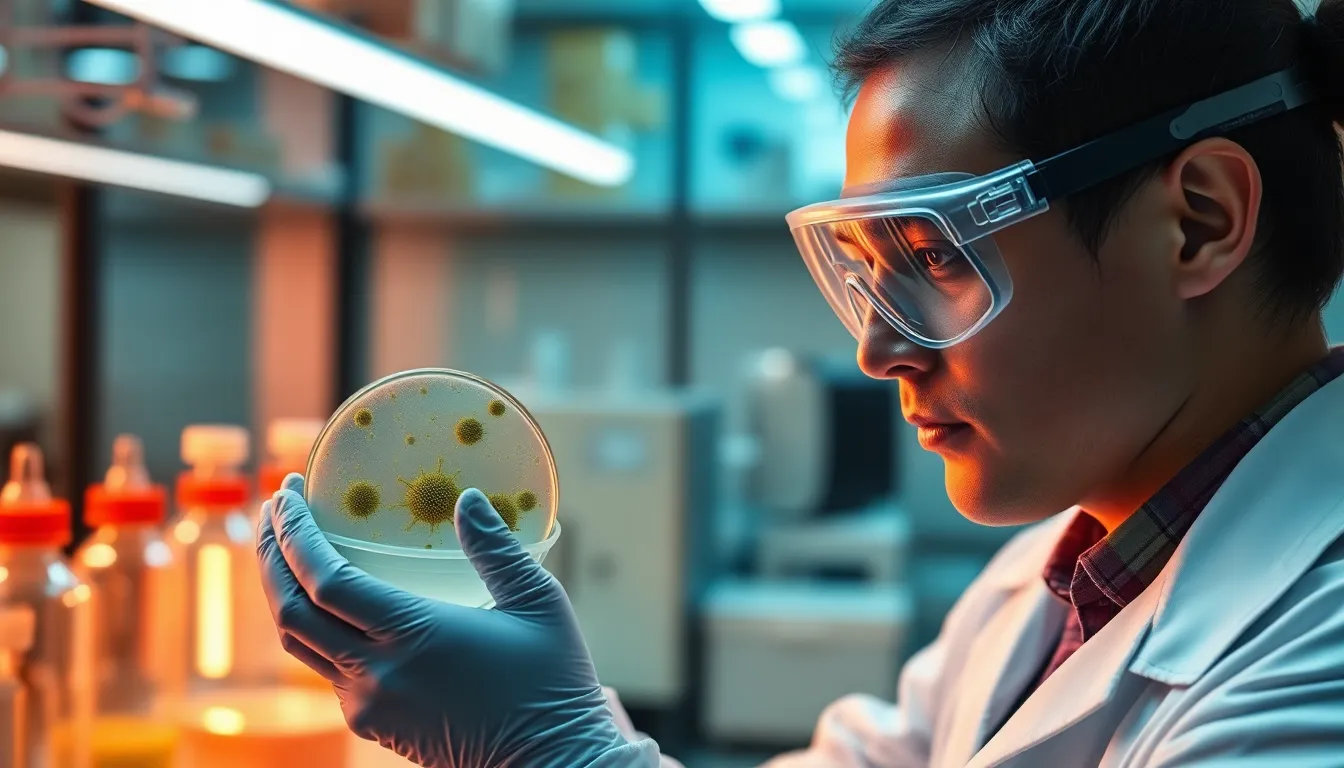

Table of Contents
ToggleIn a world where science fiction meets reality, the biotechnology industry is leading the charge. Imagine a realm where tiny organisms and advanced technology join forces to tackle some of humanity’s biggest challenges. From developing life-saving drugs to creating sustainable food sources, biotechnology is the superhero we never knew we needed.
Overview of the Biotechnology Industry
The biotechnology industry plays a crucial role in enhancing human health and agriculture. According to market analysis, the global biotechnology sector was valued at approximately $752 billion in 2020 and is projected to reach $2.44 trillion by 2028, demonstrating substantial growth in various subfields.
Life sciences represent a significant area within biotechnology. This includes drug discovery and development, where innovative treatments emerge from genetic research. Companies focus on using heredity information to create targeted therapies, leading to improved patient outcomes.
Agricultural biotechnology addresses challenges related to food production. By developing genetically modified organisms (GMOs), it increases crop yields and resistance to pests. Studies indicate that utilizing GMOs can enhance food security, especially in developing regions.
Moreover, environmental biotechnology targets sustainability. It involves using biological processes to reduce pollution and manage waste. Techniques like bioremediation employ microorganisms to clean contaminated environments, providing eco-friendly solutions.
Biomanufacturing represents another vital component, optimizing production processes. Techniques such as fermentation harness microorganisms, creating products like enzymes and biofuels. This efficiency contributes to reduced costs and lower environmental impact.
As the biotechnology industry continues evolving, regulatory frameworks adapt accordingly. Governments implement guidelines to ensure safety and efficacy while encouraging innovation. Collaborations between academic institutions and private companies facilitate knowledge transfer, offering significant opportunities for research advancements.
Investment in biotechnology research enhances global health solutions and supports economic growth. The industry stands at the forefront of technological advancement, improving quality of life through science-based strategies.
Key Segments of the Biotechnology Industry
The biotechnology industry comprises several key segments, each addressing critical needs in modern society. These segments include medical biotechnology, agricultural biotechnology, and industrial biotechnology.
Medical Biotechnology
Medical biotechnology plays a pivotal role in drug development and healthcare advancements. It focuses on creating pharmaceuticals, vaccines, and diagnostic tools that improve patient outcomes. In 2020, the global biotechnology market in medicine was valued at $469.3 billion. Innovations such as monoclonal antibodies and gene therapies showcase its impact on treating complex diseases. This segment fosters collaboration with research institutions and emphasizes regulatory compliance to ensure safety and efficacy of products.
Agricultural Biotechnology
Agricultural biotechnology enhances food production and sustainability through genetic engineering. Techniques like CRISPR are employed to create genetically modified organisms that resist pests and tolerate drought. As of 2021, biotech crops contributed to an increase of 1.4 billion tons in global food production. This segment addresses food security concerns while reducing the environmental impact of agriculture. Collaboration between biotech companies and farmers facilitates the adoption of these technologies, ensuring improved yields and resource efficiency.
Industrial Biotechnology
Industrial biotechnology focuses on optimizing production processes and creating sustainable materials. It employs microorganisms and enzymes to produce biofuels, bioplastics, and biochemicals from renewable resources. In 2019, the global market for industrial biotechnology reached $429.6 billion. This segment reduces reliance on fossil fuels and promotes eco-friendly alternatives. Companies in this field partner with industries to develop innovative manufacturing techniques, emphasizing efficiency and cost-effectiveness while minimizing environmental footprints.
Major Players in the Biotechnology Industry
Significant corporations and innovative startups shape the biotechnology landscape. These entities drive advancements and ensure substantial contributions to global health and sustainability.
Leading Companies
Biogen, Amgen, and Gilead Sciences lead the biotechnology sector. Biogen specializes in therapies for neurological diseases, gaining a market value of approximately $40 billion in 2020. Amgen focuses on biotechnology-based medications, achieving revenue of around $25 billion in recent years. Gilead Sciences is known for antiviral therapies, particularly its treatment for HIV, contributing to a market cap exceeding $70 billion. Sanofi and Roche also play pivotal roles, with Sanofi advancing in immunotherapy and Roche excelling in diagnostics, reflecting the diverse approaches within the industry.
Emerging Startups
Numerous startups are reshaping the biotechnology landscape. Moderna, known for its mRNA vaccine against COVID-19, exemplifies innovative success with a market capitalization surpassing $80 billion as of October 2021. CRISPR Therapeutics, pioneering gene-editing technologies, secures its place among rising companies with a focus on treating genetic diseases. Elsewhere, Relay Therapeutics leverages protein motion to enhance drug discovery efforts, showcasing creativity in therapeutic development. These startups represent crucial advancements, addressing various health challenges and enhancing therapeutic options.
Innovations and Trends in Biotechnology
Innovations in biotechnology drive advancements across various fields. The industry embraces cutting-edge technologies to solve pressing global issues.
Gene Editing Technologies
Gene editing has transformed biotechnology with techniques like CRISPR. The technology enables precise modifications to DNA sequences, enhancing agricultural productivity and disease resistance in crops. According to recent data, genetically modified organisms (GMOs) have contributed an increase of 1.4 billion tons in global food production as of 2021. Medical applications also benefit, with gene therapies emerging to treat genetic disorders. As more startups and established companies develop these tools, their potential impacts on health and sustainability expand, positioning gene editing as a cornerstone of modern biotechnology.
Biomanufacturing Innovations
Biomanufacturing continues to evolve through innovative processes such as fermentation. Efficient production methods reduce waste while creating sustainable materials, reflecting a shift toward eco-friendly practices. In 2019, the market for industrial biotechnology reached $429.6 billion, emphasizing its significance in creating alternatives to fossil fuels. Enhanced biomanufacturing processes optimize resource use, lowering costs and increasing productivity. With a focus on sustainability, organizations explore new methods that harness biological systems, further solidifying biomanufacturing’s role in the biotechnology landscape.
Challenges Facing the Biotechnology Industry
Challenges significantly impact the biotechnology industry’s growth and innovation strategies. Companies face various obstacles that can hinder their progress in developing new products and technologies.
Regulatory Hurdles
Regulations present a complex landscape for the biotechnology industry. Approval processes for new therapies and products often involve extensive clinical trials and lengthy documentation. Moreover, regulatory agencies, such as the FDA in the United States, require high standards of safety and efficacy. Delays in obtaining approvals can lead to increased costs and longer timeframes for product launches. Navigating these regulations demands substantial resources and expertise, affecting small startups more than established corporations. Hence, adapting regulations to keep pace with technological advancements becomes essential for fostering innovation.
Ethical Considerations
Ethical considerations play a crucial role in shaping public perception and acceptance of biotechnology. Concerns regarding genetic modification and cloning technologies raise questions about safety and morality. Some groups fear unintended consequences on ecosystems and human health. Transparency in research and development is vital to address these concerns effectively. Engaging with stakeholders helps build trust and educates the public about the potential benefits of biotechnological advancements. Therefore, ethical frameworks must evolve alongside technological progress to ensure responsible practices in biotechnology.
The biotechnology industry stands as a beacon of innovation and progress in addressing some of the world’s most pressing challenges. Its ability to merge biology with technology not only fosters advancements in healthcare and agriculture but also paves the way for sustainable practices that benefit the environment.
As the industry continues to grow and evolve, the importance of collaboration and adaptive regulatory frameworks cannot be overstated. These elements are vital for nurturing creativity and ensuring safety in groundbreaking developments.
With ongoing investment and research, biotechnology holds the promise of transforming lives and enhancing global well-being, making it an indispensable part of our future.